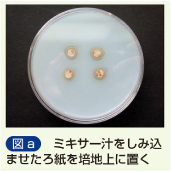

本アプリは,ユーザーを印刷物から,動画や音声,シミュレーションなどのコンテンツに誘導するアプリです。 「COCOAR2」を起動し対象物をカメラで認識させると,ひも付けられている様々なWebコンテンツを表示することができる画像認識アプリです。 COCOAR2アプリのダウンロードは,スマートフォン、またはタブレット端末より、ご利用のアプリストアへアクセスしてください。
●iPhone/iPad/iPod touchをご利用の場合
●Android端末をご利用の場合
※iPhone、iPad、App Storeは、米国およびその他の国々で登録されたApple Inc.の商標または登録商標です。
※Android、Google playは、Google Inc.の商標または登録商標です。
※サービス画面は実際のサービスと異なる場合があります。
※サイトの内容は、2017年2月現在のものです。サービスの内容は、予告なく変更する場合があります。
※アプリご利用の際の通信料は、お客様のご負担となります。
コンテンツの閲覧は下記の環境にて確認しております。
| スマートフォン/タブレット | iPhone5s以降 iPad Air以降 |
各種Android ※1 |
|---|---|---|
| OS | iOS10.X以上 | Android6.0 以上,8.0以下 |
| ブラウザ | Safari | Google Chrome |
| ネットワーク | インターネットに接続出来る環境が必要です。 (WiFi環境推奨) |
|
※1◎Android端末動作機種は,下記の点をご確認ください
| 動作端末について | 搭載されているAndroid OSのバージョンが、6.0 以上、8.0以下であることが前提です。 Android端末は、他のOS搭載の端末に比べ、ユーザーの自由性が高いため、端末固有の問題が起こる可能性があります。 |
|---|
イラストにカメラをかざして,関連する動画を見る

写真にカメラをかざして,関連する音声を聴く

そのほかにも関連画像やPDFを表示する、関連ウェブサイトにアクセスするといったことが可能になります。
動画や音声,シミュレーションなどの展開されますコンテンツは横画面推奨となります。
平成29・30年度以降版高校教科書 マーカー 一覧

p9_図4『等速直線運動をする模型自動車のストロボ写真』

p25_例題3の図『等加速度直線運動 例題の再現』

p25_問17の図『等加速度直線運動 問いの再現』

p37_章末問題②の図『等加速度直線運動 章末問題の再現』

p42_図7『力の分解』

p46_問5の図『作用・反作用 問いの再現』

p47_問6の図『作用・反作用と2力のつり合い 問いの再現』

p59_例題4の図『運動方程式 例題の再現1』

p60_例題5の図『運動方程式 例題の再現2』

p68_図30『力と圧力』

p138_図5『単振動と正弦波の波形』

p143_図12『縦波』

p146_図14『波の独立性と重ね合わせの原理』

p149_図18『自由端反射と固定端反射』

p150_図19a『自由端反射』

p150_図19b『固定端反射』

p189_図2『直流電流がつくる磁界』

p189_参考『円形電流がつくる磁界』

p191_図5『電磁誘導の実験(コイル)』

p192_問3(の図)『手まわし発電機』
![]()
p192_やってみようの図『リニアモーターと直流発電』

p193_図8『直流と交流』

p202_図B『電流計の使い方』

p203_図E『電圧計の使い方』


p.10_図8 『等速直線運動をする模型自動車のストロボ写真』

p.11_問7の図 『x-tグラフ 問いの再現』

p.21_例題の図 『等加速度直線運動 例題の再現』

p.35_図7 『力の分解』

p.38_問5の図 『作用・反作用 問いの再現』

p.39_問6の図 『作用・反作用と2力のつり合い 問いの再現』

p.49_例題4の図 『運動の法則 例題の再現1』

p.50_例題5の図 『運動の法則 例題の再現2』

p.56_図29 『力と圧力』

p.105_図6 『単振動と正弦波の波形』

p.110_図13 『縦波』

p.116_図20 a 『自由端反射』

p.116_図20 b 『固定端反射』

p.142_図B『電流計』

p.143_図E 『電圧計』

p.144_図2 『直線電流がつくる磁界』

p.146_図7『電磁誘導の実験(コイル)』

p.147_やってみようの図 『手まわし発電機』

p.148_図9 『直流と交流』


p25_図6左半分『赤ワインの蒸留』

p25_図6右半分『蒸留装置』

p26_図8左『ヨウ素の抽出(分泌ろうと)』

p26_図8右『抽出のしくみ(分泌ろうと)』

p27_図10上写真『ペーパークロマトグラフィー』

p27_図10下図『ペーパークロマトグラフィーのしくみ』

p29_図12『水素と酸素の化合』

p30_図13『ゴム状硫黄(黄色)』

p31_図15『炎色反応』

p32_図16『塩化物イオンの検出』

p33_大理石の写真『大理石の成分元素』

p34 図18上写真『臭素の拡散』

p34_図18下図『気体の拡散』

p49_図7『ナトリウムイオンの生成』
![]()
p49_図8『塩化物イオンの生成』
![]()
p54_カリウムの写真『カリウムと空気の反応』

p54_リチウムの写真『リチウムと空気の反応』

p54_カルシウムの写真『カルシウムと空気の反応』

p54_ナトリウムの写真『ナトリウムと空気の反応』

p63_図3左『塩化ナトリウムの結晶』

p63_図3右『塩化セシウムの結晶』

p89_やってみよう②の写真『銅の延性』

p138_図4『アンモニアと塩酸の反応』

p141_図7左『酸の電気伝導性』

p141_図7右『強酸と弱酸の電離』

p145_図11上部『pH指示薬メチルオレンジ(MO)』
![]()
p145_図11下部『pH指示薬フェノールフタレイン(PP)』
![]()
p150_図13『中和滴定』

p176_図9『金属と希塩酸の反応』

p177 図10『銀樹(銅+硝酸銀水溶液)』

p177_図11『鉛樹(亜鉛+酢塩酸(II)水溶液)』

p178_図12『金属と水の反応』


p12_写真左上 ステージ上下顕微鏡『顕微鏡の使い方』

p16_接眼ミクロメーターの図『ミクロメーターの使い方』

p37_図aイシクラゲの写真『原核生物(イシクラゲ)の観察』

p45_カタラーゼの実験の方法①『カタラーゼの性質』

p52_図a『花や果実の色』

p54_図e『花や果実の色素とpH』

p62_図1『DNA』

p77_図9『体細胞分裂と減数分裂』

p82_図d『リゾチーム』

p87_図Bの①『翻訳のしくみ』

p89_図a『DNAとRNAの染色による検出』

p94_図a『細胞周期の各期に要する時間の推測』

p111_図10『心臓と血流の観察 発生初期の心臓』

p118_図17『ゾウリムシの収縮胞』

p122_図a『血球と塩類濃度(ヒツジの血液)』

p122_図a『原形質分離の観察』

p131_図29右下ランゲルハンス島『すい臓とランゲルハンス島の観察』

p143_図bの左写真『白血球(マウスなど)の食作用』

p158_図a『腎臓の構造』

p171_右下イラスト『陽葉と陰葉の比較』

p197_図a『分解者による落葉の分解』
p203_ゲンゲの根『根粒と根粒菌の観察』


p8_図ⅰ.図ⅱ『地球の形と自転について調べる』

p17_図2『3種のプレートの境界』

p22_図13『ホットスポットとプレートの動き』

p28_図20『海溝型地震』

p32_図24『いろいろな断層』

p35_図28『地震計による地震動の記録』

p41_図41『沈み込み帯の火山活動』

p69_図18『不整合のでき方』
![]()
p126『転向力の実験』

p135_やってみよう 『水の上下運動』

p214_図10『液状化現象のしくみ』

p217_図ⅱ『緊急地震速報のしくみ』


p.40_例題2の図『直線上での運動量の保存 例題の再現』

p.41_問5の図 『平面内での運動量の保存 問いの再現』

p.43_図B 『重心の運動』

p.47_問7の図 『2物体の衝突 問いの再現』

p.93_問題④の図 『楕円軌道を描く人工衛星 章末問題の再現』

p.145_図15 『波の干渉』

p.148_図17 『波の回折』

p.149_図19 『波の反射』

p.150_図21 『波の屈折』

p.152_図22 『ホイヘンスの原理』

p.181_図9 『偏光板による偏光』

p.197_実験5の図 『【実験】ヤングの実験』

p.212_図1 『電気の正負』

p.233_やってみようの図 『【やってみよう】静電遮蔽』

p.234_図20 『コンデンサーの充電と放電』

p.304_やってみようの図 『自己誘導』

p.335_実験10の図 『【実験】ヘルツの実験』

p.384_実験12の図 『【実験】霧箱の制作と放射線の観察』


p.29_例題3の図『等加速度直線運動 例題の再現』

p.29_問20の図 『等加速度直線運動 問いの再現』

p.52_問5の図 『作用・反作用の法則 問いの再現』

p.53_問6の図 『作用・反作用と2力のつり合い 問いの再現』

p.124_例題2の図 『直線上での運動量の保存 例題の再現』

p.125_問5の図 『平面内での運動量の保存 問いの再現』

p.127_図B 『重心の運動』

p.131_問7の図 『2物体の衝突 問いの再現』

p.242_図5 『単振動と正弦波の波形』

p.251_図16 『縦波の波形の表し方』

p.258_図23a 『自由端反射』

p.258_図23b 『固定端反射』

p.262_図27 『波の干渉』

p.265_図29 『波の回折』

p.266_図31 『波の反射』

p.267_図33 『波の屈折』

p.269_図34 『ホイヘンスの原理』

p.313_図9 『偏向板による偏光』

p.329_実験12の図 『【実験】ヤングの実験』


p.6_図1『電気の正負』

p.26_実験2の図 『【実験】等電位線の作図』

p.29_やってみようの図 『【やってみよう】静電遮蔽』

p.30_図22 『コンデンサーの充電と放電』

p.74_図6 『直線電流がつくる磁界』

p.76_図7 『円形電流がつくる磁界』

p.94_図1 『電磁誘導の実験(コイル)』

p.104_やってみようの図 『自己誘導』

p.112_図18 『直流と交流』

p.138_実験6の図 『【実験】ヘルツの実験』

p.145_図A,図B 『【探究活動】RLC直列回路の共振』

p.188_実験8の図 『【実験】霧箱の制作と放射線の観察』


p.18_図18 『ダイヤモンドの結晶構造と単位格子』

p.19_例題2 『ダイヤモンドの原子半径と密度』

p.27_図8 『体積と蒸気圧の関係』

p.30_やってみようの写真 『二酸化炭素の液化』

p.56_図8『ヘンリーの法則』

p.70_図21 『チンダル現象』

p.101_図2 『ダニエル電池』

p.102_やってみようの写真『ダニエル電池』

p.124_図7 『温度と反応の速さ』

p.126_図9 『粒子の衝突回数』

p.148_図7上『温度変化と平衡移動』

p.148_図7下 『温度変化と平衡移動』

p.199_表7斜方硫黄の写真 『斜方硫黄をつくる』

p.199_表7単斜硫黄の写真『単斜硫黄をつくる』

p.199_表7ゴム状硫黄の図 『ゴム状硫黄(褐色)』

p.199_表7ゴム状硫黄の写真 『ゴム状硫黄(黄色)をつくる』

p.215_図4『金属と水の反応(濡れたろ紙上)』

p.245_図12 『金属イオンの分離』

p.280_図7 『シクロヘキサンの立体異性体』

p.282_図8『鎖式炭化水素の結合と回転』

p.288_図15エタンの写真 『エタンと臭素の反応』

p.288_図15エチレンの写真 『エチレンと臭素の反応(付加反応)』

p.288_図15アセチレンの写真『アセチレンと臭素の反応(付加反応)』

p.301_図7上 『アルデヒドによる銀鏡反応』

p.301_図7下 『アルデヒドによるフェーリング液の還元』

p.325_図6 『フェノール類の呈色反応』

p.332_図21 『アニリンの呈色反応』

p.397_実験の図①~④ 『ナイロン66の合成』

p.418_図5の写真『陽イオン交換樹脂』

p.419_図6の写真 『陰イオン交換樹脂』


p.26_図26『ナトリウムチャネル』

p.27_図28 『ナトリウムポンプ』

p.36_図46の一番上の図 『基質濃度と反応速度』

p.54_図7 『ミトコンドリアの電子伝達系とATP合成酵素』

p.56_p56ページ全体 『脱水素酵素の反応』

p.59_p59ページ全体 『作用・反作用と2力のつり合い 問いの再現』

p.65_p65ページ全体 『緑葉中の色素の分離』

p.67_図14 『葉緑体の電子伝達系とATP合成酵素』

p.79_図5 『DNA複製の分子メカニズム』

p.86_図10 『翻訳のしくみ』

p.101_図24左半分 『PCR』

p.101_図24右半分 a 『自由端反射』

p.102_図25 『電気泳動』

p.103_図29『塩基配列決定法』

p.144_p144ページ全体 『ウニの発生の観察』

p.146_p146ページ全体 『アフリカツメガエルの発生』

p.171_p171ページ全体『花粉管の観察』

p.194_図14 『静止電位と活動電位』

p.195_図15 『活動電位とイオンチャネル』

p.198_図22 『伝達』

p.207_図31 『骨格筋の収縮機構』

p.208_図32 『骨格筋の収縮制御』


p.22_図17『走時曲線』

p.30_図26(P波) 『P波の伝わり方と地球の層構造』

p.30_図26(S波) 『S波の伝わり方と地球の層構造』

p.65_図28 『地震波トモグラフィーの原理』

p.97_図34 『マグマの結晶分化作用の一例』

p.148_図52 『炭素14の壊変』
